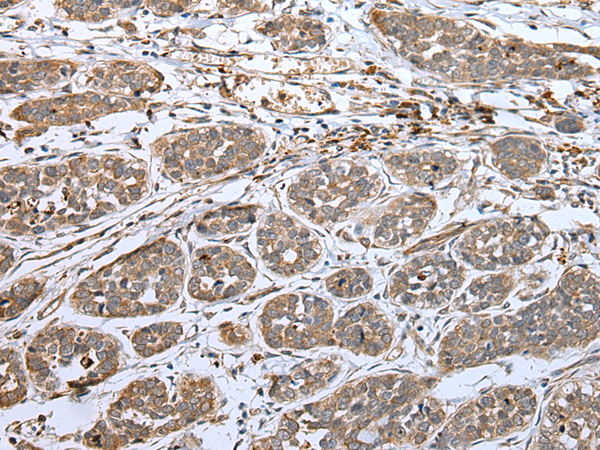

|
Background: |
This gene encodes a member of the BMP (bone morphogenic protein) antagonist family. Like BMPs, BMP antagonists contain cystine knots and typically form homo- and heterodimers. The CAN (cerberus and dan) subfamily of BMP antagonists, to which this gene belongs, is characterized by a C-terminal cystine knot with an eight-membered ring. The antagonistic effect of the secreted protein encoded by this gene is likely due to its direct binding to BMP proteins. As an antagonist of BMP, this gene may play a role in regulating organogenesis, body patterning, and tissue differentiation. In mouse, this protein has been shown to bind Nodal and to inhibit the Nodal signaling pathway which patterns left/right body asymmetry. |
|
Applications: |
ELISA, IHC |
|
Name of antibody: |
DAND5 |
|
Immunogen: |
Full length fusion protein |
|
Full name: |
DAN domain family member 5, BMP antagonist |
|
Synonyms: |
SP1; CER2; COCO; CRL2; CERL2; DANTE; GREM3; CKTSF1B3 |
|
SwissProt: |
Q8N907 |
|
ELISA Recommended dilution: |
5000-10000 |
|
IHC positive control: |
Human esophagus cancer |
|
IHC Recommend dilution: |
25-100 |
購物車
購物車 幫助
幫助
 021-54845833/15800441009
021-54845833/15800441009
